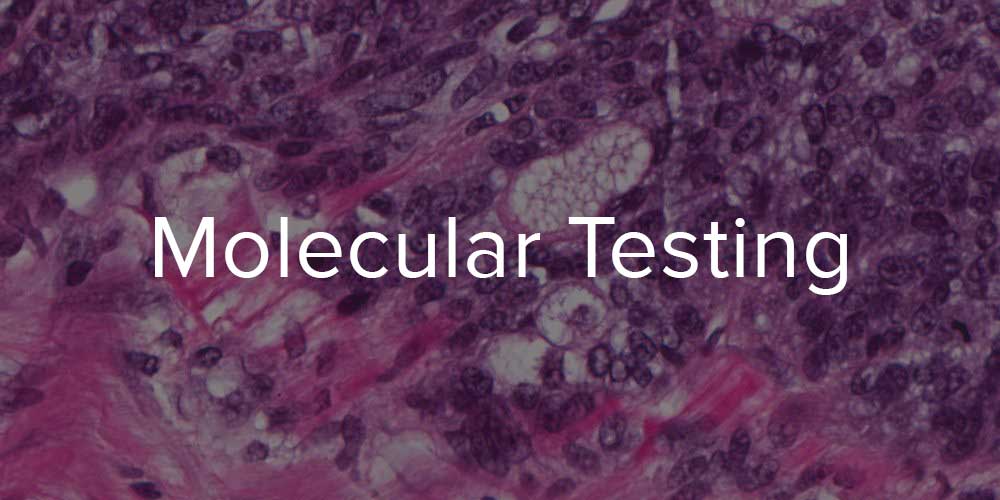

1
2
3
4
5

The University of California, San Francisco. ©2014 - 2016 The Regents of the University of California
UCSF Dermatopathology and Oral Pathology Service | 1701 Divisadero St. Suite 280 | San Francisco, CA 94115
Phone: (415) 353-7546 Toll Free: (800) 497-0244 Fax: (415) 353-7543
CLIA ID: 05D0669292 CA LAB LIC: CLF00011278
Web design by Dayspring Studio